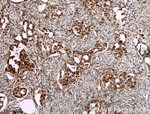
SMARCA2 Antibody in Immunohistochemistry (Paraffin) (IHC (P))

Search
Proteintech
SMARCA2 Polyclonal Antibody
{{$productOrderCtrl.translations['antibody.pdp.commerceCard.promotion.promotions']}}
{{$productOrderCtrl.translations['antibody.pdp.commerceCard.promotion.viewpromo']}}
{{$productOrderCtrl.translations['antibody.pdp.commerceCard.promotion.promocode']}}: {{promo.promoCode}} {{promo.promoTitle}} {{promo.promoDescription}}. {{$productOrderCtrl.translations['antibody.pdp.commerceCard.promotion.learnmore']}}
产品信息
26613-1-AP
种属反应
已发表种属
宿主/亚型
分类
类型
抗原
偶联物
形式
浓度
规格
纯化类型
保存液
内含物
保存条件
运输条件
产品详细信息
Immunogen sequence: MSTPTDPGA MPHPGPSPGP GPSPGPILGP SPGPGPSPGS VHSMMGPSPG PPSVSHPMPT MGSTDFPQEG MHQMHKPIDG IHDKGIVEDI HCGSMKGTGM RPPHPGMGPP QSPMDQHSQG YMSPHPSPLG APEHVSSPMS GGGPTPPQMP PSQPGALIPG DPQAMSQPNR GPSPFSPVQL HQLRAQILAY KMLARGQPLP ETLQLAVQGK RTLPGLQQQQ QQQQQQQQQQ QQQQQQQQQP QQQPPQPQTQ QQQQPALVNY NRPSGPGPEL SGP (1-272 aa encoded by NM_003070)
靶标信息
SMARCA2 encodes a protein that is a member of the SWI/SNF family of proteins and is highly similar to the brahma protein of Drosophila. Members of this family have helicase and ATPase activities and are thought to regulate transcription of certain genes by altering the chromatin structure around those genes. The encoded protein is part of the large ATP-dependent chromatin remodeling complex SNF/SWI, which is required for transcriptional activation of genes normally repressed by chromatin. Two transcript variants encoding different isoforms have been found for this gene, which contains a trinucleotide repeat (CAG) length polymorphism.
仅用于科研。不用于诊断过程。未经明确授权不得转售。
生物信息学
蛋白别名: ATP-dependent helicase SMARCA2; BAF190B; brahma homolog; BRG1-associated factor 190B; FLJ36757; global transcription activator homologous sequence; hBRM; MGC74511; Probable global transcription activator SNF2L2; Protein brahma homolog; putative global transcription activator SNF2L2; SAMRCA2; SNF2-alpha; SNF2/SWI2-like protein 2; subunit of the SWI/SNF chromatin remodeling complex; sucrose nonfermenting 2-like protein 2; SWI/SNF related, matrix associated, actin dependent regulator of chromatin, subfamily a, member 2; SWI/SNF-related matrix-associated actin-dependent regulator of chromatin a2; SWI/SNF-related matrix-associated actin-dependent regulator of chromatin subfamily A member 2; unnamed protein product
基因别名: 2610209L14Rik; BAF190; BAF190B; BIS; brahma; BRM; hBRM; hSNF2a; NCBRS; SMARCA2; SNF2; SNF2A; SNF2alpha; SNF2L2; SNF2LA; Sth1p; SWI2
UniProt ID: (Human) P51531, (Mouse) Q6DIC0
Entrez Gene ID: (Human) 6595, (Mouse) 67155